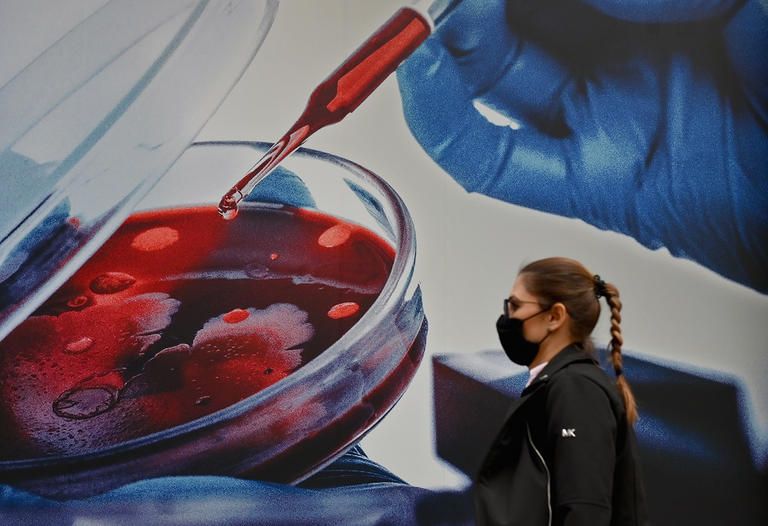
ارتفاع إصابات كورونا حول العالم لـ77 مليونا و172 ألفا و352 حالة

كورونا حول العالم.. قفزة في وفيات كوريا الجنوبية وإصابات جديدة بالصين
تواصل دول العالم إجراءاتها الاحترازية وتدابيرها الوقائية لاحتواء فيروس كورونا المستجد وكبح جماحه.
وأظهرت أحدث الإحصائيات المتعلقة بالوباء أن عدد الإصابات بلغ 77 مليونا و172 ألفا و352 إصابة, فيما سجل العالم مليونا و699 ألفا و644 وفاة، الاثنين.
وبلغ عدد المتعافين من الفيروس 54 مليونا و89 ألفا و674 متعافيا، ونستعرض فيما يلي آخر إحصائيات الفيروس حول العالم..
16 ألف إصابة جديدة في ألمانيا
قال معهد روبرت كوخ للأمراض المعدية في ألمانيا، الاثنين، إن عدد الإصابات الجديدة المؤكدة بفيروس كورونا ارتفع بواقع 16 ألفا و643 حالة إلى مليون و510 آلاف و652 حالة في المجمل.
وأضاف المعهد أنه سجل 226 وفاة ناجمة عن الفيروس مما يرفع عدد الوفيات الإجمالي إلى 26 ألفا و275.
رقم قياسي في الوفيات اليومية بكوريا الجنوبية
قالت السلطات الصحية في كوريا الجنوبية، الاثنين، إن البلاد سجلت أكبر عدد وفيات يومية بفيروس كورونا وذلك في ظل ارتفاع في عدد الإصابات شكل ضغطا على النظام الصحي ودفع الشرطة لمداهمة مقار أنشطة تجارية تشتبه بانتهاكها قواعد التباعد الاجتماعي.
وقالت المراكز الكورية لمكافحة الأمراض والوقاية إنها سجلت 24 وفاة جديدة مما يرفع العدد الإجمالي إلى 698.
وسجلت البلاد أيضا 926 حالة إصابة جديدة بالفيروس نزولا من الرقم القياسي البالغ 1097 يوم الأحد.
وتجاوز العدد الإجمالي لحالات الإصابة في البلاد 50 ألف حالة وفقا لأحدث بيانات.

118 ألفا و202 وفاة في المكسيك
قالت وزارة الصحة المكسيكية إنها سجلت 6870 حالة إصابة جديدة مؤكدة بفيروس كورونا و326 وفاة مما يرفع العدد الإجمالي للإصابات في البلاد إلى مليون و320 ألفا و545 حالة في حين وصل عدد الوفيات إلى 118 ألفا و202.
وتقول الحكومة إن العدد الفعلي للإصابات أكبر بكثير على الأرجح من العدد المعلن.

23 حالة عدوى جديدة بالصين
قالت لجنة الصحة الوطنية في الصين، الاثنين، إن البر الرئيسي سجل 23 حالة إصابة جديدة بفيروس كورونا، الأحد، وهو نفس العدد المسجل، السبت.
وأكدت اللجنة في نشرتها اليومية أن 21 من الحالات الجديدة قادمة من الخارج.
ويصل بذلك العدد الإجمالي لحالات الإصابة المؤكدة بكوفيد-19 في الصين إلى 86852 بينما يظل عدد الوفيات ثابتا عند 4634.

408 وفيات جديدة في البرازيل
قالت وزارة الصحة بالبرازيل إنها سجلت 25445 حالة إصابة جديدة بفيروس كورونا، لكنها نبهت إلى أن الأرقام المعلنة لا تضم بيانات ولاية ساو باولو بسبب مشكلات فنية.
وسجلت الوزارة أيضا 408 وفيات بمرض كوفيد-19 الناجم عن الإصابة بالفيروس.
الهند تسجل 24337 إصابة جديدة
أظهرت بيانات وزارة الصحة الهندية، الاثنين، تسجيل 24337 حالة إصابة جديدة بفيروس كورونا مما يرفع العدد الإجمالي في البلاد إلى 10.06 مليون.
وقالت الوزارة إنها سجلت 333 وفاة بالفيروس خلال الساعات الأربع والعشرين الماضية مشيرة إلى أن العدد الإجمالي وصل إلى 145 ألفا و810 وفيات.
